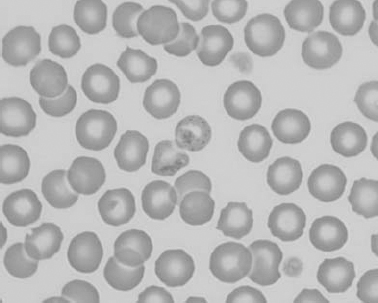
img
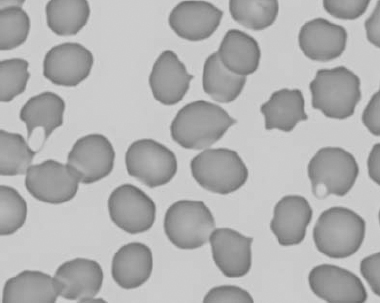
img
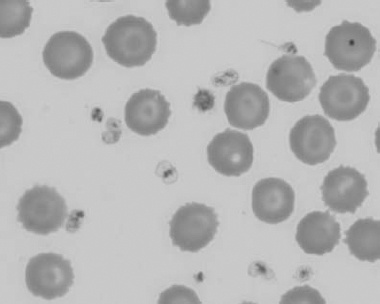
img
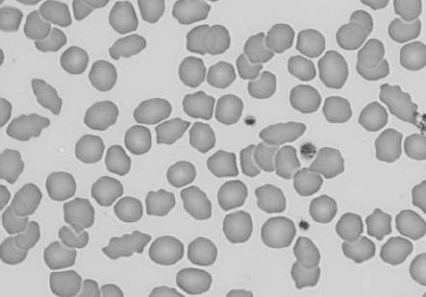
img
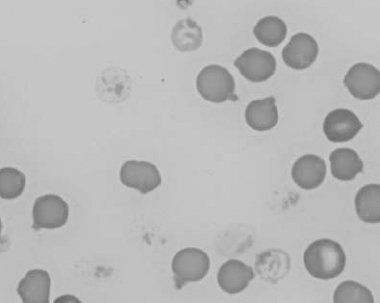
img
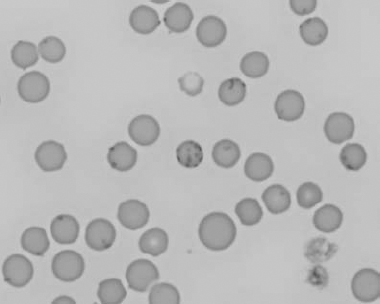
img
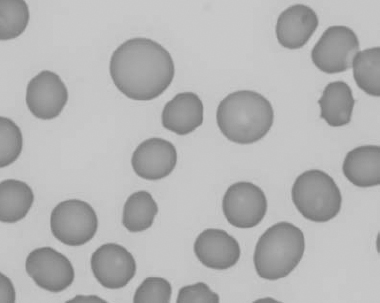
img
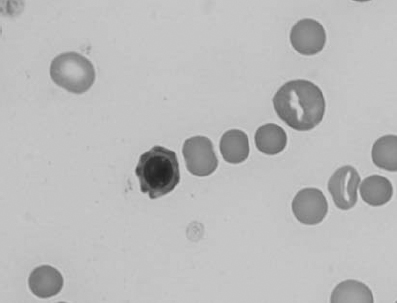
img
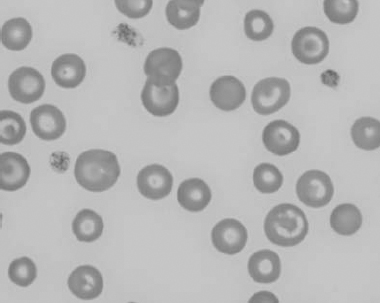
img
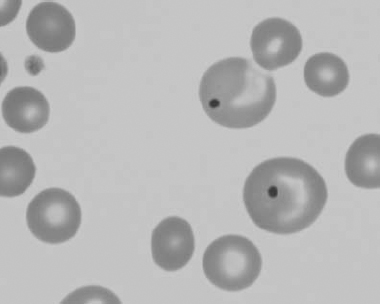
img
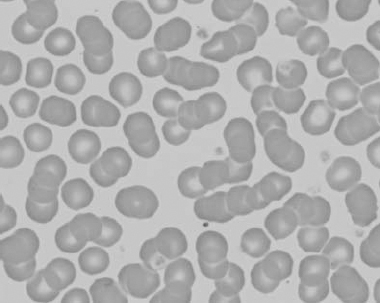
img
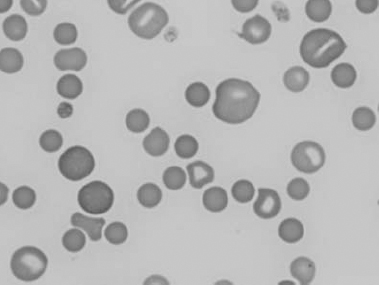
img

Contents
Preface
Acknowledgments
1 Erythrocytes
Erythropoiesis
Erythrocyte morphology
Erythrocyte metabolism
Erythrocyte values
Anemia
Erythrocytosis
Nuggets
Case studies
Glossary
Color Section
2 Leukocytes
Granulopoiesis
Interpreting the leukogram
Nuggets
Case studies
Glossary
3 Hemopoietic Neoplasia
Myeloid neoplasms
Lymphoid neoplasms (see Table 3.3)
Case studies
Glossary
4 Hemostasis
Primary hemostasis
Secondary hemostasis
Fibrinolysis and anticoagulation
Laboratory evaluation of hemostasis
Disseminated intravascular coagulation and fibrinolysis
Nuggets
Case studies
Glossary
5 Cytology
Evaluation of fluid samples
Specific fluid types
Other body fluids and washes
Solid tissues
Nuggets
Case studies
Glossary
6 Fluids, Electrolytes, and Acid-Base Balance
Body water
Abnormal body water balance
Laboratory evaluation of water balance
Serum electrolytes
Osmotic pressure
Anion gap
Acid–base balance
Nuggets
Case studies
Glossary
7 Renal System
Urinalysis
Fractional excretion of electrolytes
Miscellaneous laboratory findings with renal disease
Nuggets
Case studies
Glossary
8 Hepatobiliary System
Enzymes
Indicators of hepatocellular injury
Indicators of cholestasis
Indicators of hepatic dysfunction
Expected results according to hepatic disorder
Nuggets
Case studies
Glossary
9 Digestive System
Acid–base and electrolyte disturbances
Grain overload
Gastritis
Intestinal hemorrhage
Equine colic
Canine hemorrhagic gastroenteritis
Exocrine pancreatic disease
Maldigestion and malabsorption
Protein-losing enteropathy
Nuggets
Case studies
Glossary
10 Endocrine System
Parathyroid glands
Thyroid gland
Pituitary gland and adrenal glands
Endocrine pancreas
Nuggets
Case studies
Glossary
11 Muscle
Glossary
12 Lipids and Proteins
Lipids
Proteins
Glossary
Appendix I Practice Cases
Appendix II Interpretation of Laboratory Results
Appendix III Guide to Case Studies
Glossary
Bibliography
Index

Marion L. Jackson, DVM, MVetSc, PhD is a diplomate of the American College of Veterinary Pathologists and a professor in the Department of Veterinary Pathology at the Western College of Veterinary Medicine, University of Saskatchewan
marion.jackson@usask.ca
© 2007 Blackwell Publishing
All rights reserved
Blackwell Publishing Professional
2121 State Avenue, Ames, Iowa 50014, USA
Orders: 1-800-862-6657
Office: 1-515-292-0140
Fax: 1-515-292-3348
Web site: www.blackwellprofessional.com
Blackwell Publishing Ltd
9600 Garsington Road, Oxford OX4 2DQ, UK
Tel.: +44 (0)1865 776868
Blackwell Publishing Asia
550 Swanston Street, Carlton, Victoria 3053, Australia
Tel.: +61 (0)3 8359 1011
Authorization to photocopy items for internal or personal use, or the internal or personal use of specific clients, is granted by Blackwell Publishing, provided that the base fee of $.10 per copy is paid directly to the Copyright Clearance Center, 222 Rosewood Drive, Danvers, MA 01923. For those organizations that have been granted a photocopy license by CCC, a separate system of payments has been arranged. The fee codes for users of the Transactional Reporting Service are
ISBN-13: 978-0-8138-2140-5;
ISBN-10: 0-8138-2140-1/2007 $.10.
First edition, 2007
Library of Congress Cataloging-in-Publication Data
Jackson, Marion L.
Veterinary clinical pathology: an introduction / Marion L. Jackson.–1st ed.
p. cm.
Includes bibliographical references and index.
ISBN-13: 978-0-8138-2140-5 (alk. paper)
ISBN-10: 0-8138-2140-1 (alk. paper)
1. Veterinary clinical pathology. I. Title.
SF772.6.J33 2006
636.089′607–dc22
2006001949
The last digit is the print number: 9 8 7 6 5 4 3 2 1
Preface
At the Western College of Veterinary Medicine, students are introduced to Clinical Pathology in year three of the undergraduate program. In year four, small groups of students rotate through the laboratory, which provides a dynamic setting to test and expand their knowledge. Several years ago, Dr. Gene Searcy, the most enthusiastic clinical pathologist I have known, made a dramatic change in the third-year course, by moving from didactic lectures with a few case examples, to case studies interjected with a few minilectures. Dr. Beverly Kidney, my colleague, and I have continued with this format, which is very well received by our students. Assigned readings provide the tools needed to understand and interpret laboratory data, and during classes, students are randomly chosen to discuss laboratory results from a book of case studies.
This textbook has evolved from the reading assignments for the undergraduate course and is intended to give the student a sound knowledge base with which to work. The book is not heavily referenced other than with standard physiology, clinical pathology, and medicine textbooks, and is not intended to be a review of the current literature. I have aimed for a clear, concise presentation of basic mechanisms without overwhelming the student. Cases at the end of each chapter (except Chapters 11 and 12) emphasize basic principles discussed in the text. The cases are real and, therefore, are not perfect. Not all results can be satisfactorily explained, which is true to life. Students are encouraged to interpret the case data on their own before reading my version. Complete interpretations are provided even though the student may not be familiar with all laboratory data until completion of the book. It is expected that instructors using this book will provide additional cases from their own diagnostic service for class discussion and to challenge the students. Laboratory periods complement our course by affording the opportunity to learn practical aspects of performing a CBC, blood and cytology smear evaluation, and doing a urinalysis.
If we as instructors can help students to become proficient in applying clinical pathology as a powerful diagnostic tool, then we have been successful. We are overjoyed when students grasp this subject and run with it; let us make it fun too.
Acknowledgments
I thank my mentor, Dr. Gene Searcy, and colleague, Dr. Beverly Kidney, for their encouragement and support with this project. Undergraduate students, graduate students, clinicians, technologists, staff, and colleagues within the Western College of Veterinary Medicine and Prairie Diagnostic Services have helped me to improve my teaching and writing, with their invaluable input, feedback and challenging questions. No doubt, I have made errors of various types in this book, and I welcome criticism and comments for improvements (please send me an e-mail: marion.jackson@usask.ca).
The whim to write this book only took root as a project for a sabbatical leave—a vital part of academic life. Dr. Nicole Fernandez, a former graduate student in our department, was of great assistance with the photographs, figures, tables, proofreading, and organization of the book. Dr. Juliane Deubner, our college medical illustrator and treasured resource, generated most of the figures, and Ms. Maeve Johnston, graphic designer and illustrator, drew the cells for the figures and the tables of erythrocyte morphology. I thank Ms. Priscilla Neufeld for her usual competence and reliability, and for working long and odd hours on the final product. The data for the case studies were generated by Prairie Diagnostic Services, which employs a team of veterinary professionals and technologists second to none. Mrs. Gloria Patry, Prairie Diagnostic Services, kindly provided the photographs of urine sediment findings. Ms. Kim Christiansen, Prairie Diagnostic Services, helped immensely with loose ends when deadlines loomed. Production staff of Blackwell Publishing are to be thanked for their guidance and creation of this textbook.
I am grateful to my husband, Dr. Vladimir Sopuck, and sons, Adam and Bennett, for supporting me through another adventure.
The production of erythrocytes from stem cell to mature circulating red blood cell (RBC) is known as erythropoiesis. Hemopoiesis refers to the production of all blood cells, including white blood cells (WBCs) and platelets. Erythropoiesis is most effective in the bone marrow, although other tissues may provide additional sites of RBC production. Erythrocytes deliver oxygen to tissues, remove carbon dioxide from tissues, and buffer acid–base changes in the circulation. Tissue oxygenation is the main regulator of RBC production, and conditions associated with tissue hypoxia stimulate the bone marrow to increase RBC production. When tissue oxygenation is adequate, total erythroid mass fluctuates very little, as a steady state exists between RBC production and RBC loss.
Hemopoietic stem cells have the ability to develop into common myeloid progenitors and common lymphoid progenitors (Fig. 1.1). Erythrocytes, megakaryocytes, and all leukocytes (except lymphocytes) are generated from common myeloid progenitors. The first level of committed differentiation to erythrocytes is within the precursor cell compartment. The bone marrow microenvironment provides the structural and biochemical support for normal hemopoiesis. Growth factors, transcription factors, adhesins, interleukins, and other mediators comprise a complex system that responds to increased demands when required and maintains a finely tuned balance under normal circumstances. The expression and availability of these factors influence the balance among the various committed lineages. Erythropoietin (EPO) is the most important growth factor for maintaining erythroid proliferation. If peripheral blood evaluation reveals an inadequate or unexplained bone marrow response, examination of the marrow is usually indicated.
The committed erythroid precursor undergoes up to five mitotic divisions over 5 days. The earliest recognizable erythroid precursor is the rubriblast, followed by differentiation sequentially to the prorubricyte, rubricyte, metarubricyte, polychromatophilic erythrocyte, and the mature erythrocyte (Fig. 1.2). Erythroid maturation correlates with a decrease in EPO receptors and an increase in transferrin receptors on the surface of red cell precursors. Transferrin receptors allow for incorporation of iron into erythrocytes, for hemoglobin synthesis. Hemoglobin comprises four globin chains, each bound to a heme molecule containing iron. Hemoglobinization of the red cell cytoplasm is most active during the rubricyte stage. Also, cell division stops during the rubricyte stage as hemoglobinization nears completion and the nucleus condenses. At the end of the metarubricyte stage, the pyknotic nucleus is extruded and phagocytized by local macrophages.
Although nucleated erythrocytes are not usually found in the peripheral blood, a low percentage of circulating polychromatophilic cells are present under normal circumstances in most species (e.g. about 1% in the dog). The horse is an exception in that immature erythrocytes are rarely released into the peripheral blood in this species, even when intense erythroid hyperplasia is occurring in the bone marrow in response to anemia. Residual ribosomes and RNA, reflecting the end of protein synthesis (mainly hemoglobin), are responsible for the purplish-blue coloration of polychromatophilic erythrocytes with Romanowsky-type stains, such as Wright–Giemsa. Polychromatophilic erythrocytes lose their residual RNA within 24–48 hours of release from the bone marrow. When blood smears are stained with new methylene blue rather than Romanowsky stains, the residual RNA in immature RBCs is precipitated in clumps and the cells are known as reticulocytes.
Figure 1.1 The cells of the blood and lymphoid organs and their precursors in the bone marrow.

In the common domestic animals, mature erythrocytes are biconcave disks that are highly deformable, allowing them to travel through small capillaries and deliver oxygen to tissues (see Table 1.1). Erythrocyte aging and certain pathological conditions can cause RBCs to assume unusual shapes, which may result in increased rigidity. Rigid RBCs are susceptible to mechanical injury and are less effective in delivering oxygen. Exposure to stagnant environments (pooling of blood in a cavernous, hypoxic space), certain serum biochemical abnormalities, antibody-mediated membrane injury, and mechanical injury can alter the normal biconcave shape. Sometimes, RBC morphologic changes are associated with specific diseases or conditions, but the mechanism of the shape change is not clear (see Table 1.1 for diagrams of various types of RBC morphology).
Figure 1.2 Erythrocyte kinetics. After stimulation by erythropoietin (EPO), cells in the committed erythroid compartment differentiate into rubriblasts, followed by mitotic division and maturation to mature erythrocytes.

See Figs 1.3–1.24 for pictures of various types of RBC morphology.
The red cell wall is a typical lipid bilayer, comprising mainly phospholipids and cholesterol (Fig. 1.25). Membrane proteins and glycoproteins are inserted into the lipid bilayer, some in one leaflet only and others spanning the entire membrane. These integral proteins include hormone receptors and enzymes, which usually only partially penetrate into the bilayer, and transmembrane proteins, which include the transport carriers for ions and water-soluble substrates, such as glucose. The transmembrane proteins maintain cation–anion homeostasis within red cells. Abnormalities in ion pumps can result in a shortened red cell lifespan.
Table 1.1 Erythrocyte morphology



Figure 1.3 Canine blood film showing acanthocytes (also see color section).

Figure 1.4 Canine blood film showing anisocytosis (also see color section).

Figure 1.5 Bovine blood film showing basophilic stippling within a macrocyte as part of the regenerative response (also see color section).

Figure 1.6 Canine blood film showing basophilic stippling due to lead toxicosis (also see color section).
Figure 1.7 Canine blood film showing blister cells due to oxidative damage (also see color section).
Figure 1.8 Canine blood film showing codocytes. Up to 50% codocytes may be normal in a dog (also see color section).
Figure 1.9 Canine blood film showing eccentrocytes due to oxidative damage (also see color section).

Figure 1.10 Canine blood film showing echinocytes I (also see color section).

Figure 1.11 Canine blood film showing echinocytes III (also see color section).

Figure 1.12 Feline blood film showing echinoelliptocytes (also see color section).
Figure 1.13 Canine blood film showing Heinz bodies and ghost cells due to oxidative damage. There are also several polychromatophils (also see color section).
Figure 1.14 Canine blood film stained with new methylene blue, to demonstrate Heinz bodies (also see color section).

Figure 1.15 Canine blood film showing keratocytes and schizocytes (erythrocyte fragments) due to fibrin strand injury. A codocyte and a polychromatophil also appear in the field (also see color section).

Figure 1.16 Feline blood film showing Mycoplasma hemofelis organisms (hemobartonellosis). Organisms are not always visible in blood smears from infected cats (also see color section).
Figure 1.17 Canine blood film showing several macrocytes (also see color section).
Figure 1.18 Canine blood film showing a metarubricyte There is also a polychromatophilic macrocyte in the field (also see color section).
Figure 1.19 Canine blood film showing microcytic, hypochromic erythrocytes consistent with iron deficiency anemia. There are two polychromatophils in the field, indicating that the anemia is regenerative (also see color section).
Figure 1.20 Canine blood film showing two macrocytes with nuclear remnants (also see color section).
Figure 1.21 Bovine (calf) blood film showing marked poikilocytosis (normal?) (also see color section).

Figure 1.22 New methylene-blue-stained Canine blood film showing reticulocytes (also see color section).

Figure 1.23 Canine blood film showing rouleaux formation (also see color section).
Figure 1.24 Canine blood film showing spherocytosis and polychromasia due to immune-mediated hemolytic anemia (also see color section).
Figure 1.25 The red blood cell cytoskeleton.

The red cell skeleton forms the scaffolding for the lipid bilayer and plays an important role in membrane stability and deformability. Deformability is the most important property of RBCs required for normal survival, particularly as cells traverse capillary beds and the exacting environment of the spleen. Interactions between skeletal proteins, such as spectrin, ankyrin, and actin, and the lipid bilayer maintain membrane shape, flexibility, and durability. The organization of membrane phospholipids is also stabilized, and cell-surface activities (e.g. anion and glucose transport) are influenced by interactions between skeletal proteins and transmembrane proteins. Skeletal proteins link to the lipid membrane via two main interactions: spectrin–ankyrin band 3 and spectrin–actin band 4.1. The bands are named according to their migration patterns on electrophoresis. Many are now assigned names that reflect their function, for example, band 3 is now known as AE1 for its role as an anion exchange protein or channel.
When reticulocytes mature and lose their mitochondria, they are no longer capable of oxidative metabolism. Mature erythrocytes derive their energy from adenosine triphosphate (ATP) generated by anaerobic glycolysis (Embden–Meyerhof pathway) (Fig. 1.26). ATP provides the energy to maintain membrane ion pumps. Defects in this pathway lead to an inability to maintain normal fluid and electrolyte content within the red cells, resulting in intravascular hemolysis or premature destruction in the spleen. Enzyme defects within a branch of the Embden–Meyerhof pathway, called the Rapaport–Luebering pathway, result in decreased production of 2,3-biphosphoglycerate (2,3-BPG, also known as 2,3-diphosphoglycerate, 2,3-DPG) with consequences of increased affinity of hemoglobin for oxygen and impaired oxygen delivery to tissues. In addition to generating ATP as an energy source, erythrocytes must be capable of preventing chemical injury (oxidative damage) from the high concentrations of oxygen that they transport. This is accomplished through two other branches of the Embden–Meyerhof pathway, the hexose monophosphate shunt and the methemoglobin reduction pathway. Glucose-6-phosphate is the substrate for the hexose monophosphate shunt which maintains glutathione in the reduced state. Reduced glutathione is an intracellular buffer that protects red cells from oxidant injury, particularly by hydrogen peroxide and the superoxide anion, and also helps to stabilize the reactive sulfhydryl groups of hemoglobin. The methemoglobin reduction pathway returns oxidized hemoglobin (methemoglobin) to its reduced state (ferrous/Fe2+) that is capable of oxygen transport.
Defects in the Embden–Meyerhof pathway that lead to ATP deficiency are manifested as hemolytic anemia due to an inability to maintain normal water and electrolyte homeostasis. Nonspherocytic but rigid erythrocytes are removed in the exacting environment of the spleen. Defects in production of 2,3-BPG result in an increased affinity of oxygen for hemoglobin, impaired oxygenation of tissues, and erythrocytosis. Defects in the hexose monophosphate shunt lead to oxidative damage to erythrocytes, hemoglobin denaturation, and Heinz body hemolytic anemia. Errors in the methemoglobin reduction pathway prohibit reduction of oxidized hemoglobin. Erythrocytes are unable to transport oxygen and cyanosis develops.
Erythrocyte morphology, number, size, and hemoglobin content are evaluated by peripheral blood smear examination and also through a combination of measurements and calculations, usually with the aid of automated instruments. These erythrocyte values include RBC count, hemoglobin (Hgb), hematocrit (Hct), mean corpuscular volume (MCV), mean corpuscular hemoglobin (MCH), mean corpuscular hemoglobin concentration (MCHC), red cell distribution width (RDW), reticulocyte count, and reticulocyte production index (RPI) (in dogs only). The RBC count, Hgb, and MCV are measured, whereas the Hct, MCH, MCHC, and RDW are calculated (Table 1.2). The RPI is calculated using the reticulocyte count, which is usually determined manually.
Figure 1.26 Erythrocyte metabolism.

Table 1.2 Erythrocyte values used in the complete blood count (CBC)

Anemia is an absolute reduction in the volume of erythrocytes in the peripheral blood and is identified by decreases in the RBC count, Hgb, and Hct (or PCV) below the reference limits for a given species. Anemias are classified in many ways, for example, according to the responsiveness of the bone marrow (regenerative vs. nonregenerative); the cause, such as blood loss, hemolysis, bone marrow failure; the morphology of the erythrocytes, such as microcytic and hypochromic; and the precise etiology, such as ingestion of an oxidizing agent, blood-borne parasite, traumatic hemorrhage, etc.
Bone marrow response to anemia, for most species, can be assessed by evaluating the peripheral blood. Blood smear examination in regenerative anemias will reveal macrocytosis and increased polychromasia and anisocytosis. Polychromasia will be reflected in an elevated reticulocyte count. Macrocytosis relates to the release of immature erythrocytes/polychromatophilic erythrocytes and this will correlate with the MCV. Theoretically, the RDW should reflect the degree of anisocytosis.
Several species release immature erythrocytes containing many small blue dots with Romanowsky stains. This is known as basophilic stippling and is most prominent in bovine regenerative anemia, but can also be seen in cats and dogs. If basophilic stippling is not accompanied by a severe anemia and robust regenerative response, a disorder in hemoglobin synthesis, such as with lead poisoning, should be considered. Increased metarubricytes, unrelated to a regenerative anemia, may also appear in the peripheral blood with lead poisoning.
Horses rarely release immature erythrocytes even when intense erythroid hyperplasia is present in the marrow in response to severe anemia. Peripheral blood findings of erythrocyte regeneration that may be, but are not necessarily, seen in the horse are increases in MCV and RDW. Bone marrow examination is required to accurately assess erythropoiesis in an anemic horse. However, the clinical information together with monitoring of the Hct over several days may obviate the need for bone marrow examination.
Nucleated RBCs (metarubricytes) may accompany a regenerative response. However, if anemia is not present, or anemia is present but metarubricytes are disproportionately high relative to the reticulocyte response, other conditions should be considered. These include hypoxia, necrosis, and metastatic cancer involving the bone marrow, lead poisoning, and erythroid neoplasia (especially in cats).
Regenerative anemia is usually due to blood loss or hemolysis. With a single episode of anemia, reticulocytes will increase in the peripheral blood by 2–4 days and peak by about 7–10 days (varying with the species). If there is no regeneration when the anemia is first detected, monitoring the peripheral blood response over several days may be necessary to determine if the bone marrow is responding appropriately.
Trauma is a frequent cause of acute external and internal blood loss. The body immediately attempts to restore the circulating volume by drawing low-protein interstitial fluid into the intravascular space. By the time blood is obtained for analysis, there is a decreased Hct, Hgb, RBC count, and total protein. Intravenous fluids that are given to restore blood volume also exacerbate the decline in Hct, Hgb, RBC count, and total protein.
Red cell breakdown products are not available for recycling when blood is lost from the body. Chronic or recurrent external blood loss can be caused by disorders of primary hemostasis, such as thrombocytopenia and von Willebrand disease; infestation with internal or external bloodsucking parasites; intestinal hemorrhage from ulcers (drug or stress induced), enteritis, or neoplasms; and genitourinary bleeding. Bleeding into the intestinal and genitourinary tracts is truly external blood loss because RBCs are not available for recycling. Iron is lost from the body and, given sufficient time, erythropoiesis is affected. Iron deficiency anemia is a continuum and, if uncorrected, microcytosis and hypochromia eventually develop. Hemoglobinization of rubricytes and metarubricytes is impaired and the delay in incorporation of iron results in an additional mitotic division in erythroid cells. This additional mitosis is responsible for microcytosis in developing erythrocytes. The lack of iron causes hypochromia in advanced cases, which is identified as pale cells with increased central pallor; fragility and fragmentation of erythrocytes due to the paucity of intracellular hemoglobin; and decreases in MCH and MCHC. Despite the lack of iron, the anemia is often regenerative at the time of initial detection. The regenerative response may not be as robust as with anemias that are not associated with iron lack, such as hemolysis or internal hemorrhage. Tests that help to confirm iron deficiency are serum iron; total ironbinding capacity (TIBC), which is a measure of transferrin, the iron-binding protein; serum ferritin; and visual evaluation of marrow iron stores. Serum ferritin and bone marrow examination are the best ways to assess total iron stores in the body. Serum iron is affected by many conditions besides iron status. However, low serum iron and high TIBC are expected in iron deficiency in most species, except the dog. In this species, the TIBC is not necessarily increased with iron deficiency. Although serum iron is also decreased with anemia related to chronic inflammation, the TIBC is low to normal with this condition. Serum ferritin assays are not readily available for all species, and bone marrow examination is an invasive procedure if iron status is the only concern. Often the history, clinical findings, and peripheral blood findings are sufficient to diagnose iron deficiency anemia. The etiology of the iron lack must then be determined.
Hemolysis can occur within the peripheral blood (intravascular), in tissues rich in macrophages such as the spleen, liver, and lymph nodes (extravascular), and sometimes in both. If significant numbers of erythrocytes are lysed in the peripheral bloodstream, hemoglobinemia and hemoglobinuria are seen. Hemolysis that occurs through the mononuclear phagocyte system (MPS) may be accompanied by icterus from overwhelming the ability of the liver to take up, conjugate, and/or secrete recycled bilirubin. Intravascular hemolysis is less common than extravascular hemolysis, in veterinary medicine. Causes of intravascular hemolysis include immune-mediated red cell destruction when accompanied by complement fixation and activation of the membrane attack complex, oxidative damage to erythrocytes, bacterial infections (e.g. with clostridial organisms), certain erythrocyte parasites (e.g. babesiosis), neonatal isoerythrolysis (particularly in horses), excessive water consumption or hypotonic fluid administration, transfusion reactions, hypophosphatemia, red cell metabolic defects (e.g. phosphofructokinase defect in dogs), and mechanical shearing of erythocytes. Causes of extravascular hemolysis include immune-mediated red cell destruction predominated by macrophage activation (idiopathic or due to viral, bacterial, parasitic, or tumor antigens attached to red cell membranes), certain red cell parasites that cause direct damage to red cell membranes (e.g. Mycoplasma organisms (formerly Hemobartonella) in cats, Anaplasma in cattle), congenital red cell defects (e.g. pyruvate kinase defect in dogs and cats), and neoplasia of macrophage-type cells (e.g. malignant histiocytosis).
Many serious underlying illnesses that are not primary hemopoietic disorders can be associated with nonregenerative anemia. Neoplasia, renal disease, inflammatory disease, and endocrinopathies, such as hypothyroidism and hypoadrenocorticism, commonly affect erythropoiesis. The pathophysiology of the anemia is well understood for some of these conditions, and not for others. For example, the anemia associated with renal failure is multifactorial, but lack of EPO is particularly important. With severe inflammatory disease, which is the most common cause of nonregenerative anemia in veterinary medicine, anemia is caused by a combination of reduced availability of iron for erythropoiesis, decreased red cell lifespan, and decreased responsiveness of the erythroid lineage to EPO. These effects are due to the presence of cytokines, particularly interleukin 1 (IL-1), tumor necrosis factor (TNF), transforming growth factor β (TGF-β), and interferon α (INF-α). Historical information, physical findings, and other test results are useful to differentiate primary bone marrow disease from secondary causes of nonregenerative anemia. Bone marrow examination is indicated when secondary causes are ruled out and the anemia is suspected to be due to bone marrow pathology. Marrow disorders to consider are erythroid hypoplasia or aplasia due to toxins, chemicals, hormones, or irradiation; dyserythropoiesis resulting in defective maturation; marrow necrosis; infiltration of the marrow with neoplastic cells or fibroblasts; viral infections such as feline leukemia virus (FeLV) or feline immunodeficiency virus (FIV); and immune-mediated destruction of erythroid precursors. With many conditions, cell lines in addition to erythroid are affected. When erythroid hypoplasia or pure red cell aplasia is found on bone marrow examination, an etiology is often not identified. Repeat evaluation of the bone marrow and monitoring of the peripheral blood response may be required to determine if the condition is reversible or irreversible. Blood transfusion and immunosuppressive therapy may be useful to provide time for the marrow to respond and to treat a possible underlying immune-mediated mechanism, respectively. Students should learn the proper technique for acquiring bone marrow and making good-quality smears, so that bone marrow evaluation can be offered to clients in situations where peripheral blood findings require further investigation.
Though less common than anemia, increases in Hct, Hgb, and RBC count are sometimes seen. Most often the increases are relative, due to dehydration. The total protein level will be elevated to the same degree unless there is a pre-existing reason for the protein to be low. In this case, the total protein may be within reference limits or mildly decreased despite the dehydration. Restoration of normal fluid balance is required to properly assess the erythrogram and total protein.
Relative erythrocytosis can also occur with splenic contraction in an extremely excited animal, particularly the horse, due to epinephrine release. Total protein is unaffected by splenic contraction.
Absolute erythrocytosis is associated with an increase in total red cell mass. Primary erythrocytosis is very uncommon and is due to neoplasia of hemopoietic cells. If the tumor is at the level of hemopoietic stem cells, then platelet and leukocyte numbers will also be elevated; otherwise, only erythrocytes are increased in the peripheral blood. EPO levels are low or within reference limits and arterial pO2 is within reference limits, since the hemopoietic cells are autonomous and not responding to the physiologic need for increased numbers. With secondary erythrocytosis, EPO levels are increased, either for physiologic reasons because tissues are not being well oxygenated, or because inappropriate levels of EPO are being produced. Causes of poor oxygenation include cardiac or pulmonary disease, leading to chronic hypoxia, and exposure to high altitudes over a long period of time. Various tumors and lesions can produce EPO, the most common being renal tumors. Absolute versus relative erythrocytosis can usually be differentiated, based on history, clinical findings, and additional laboratory findings. Primary and secondary absolute erythrocytosis can usually be differentiated, based on ancillary tests (such as radiographs, ultrasound), arterial blood gases, and EPO levels.
Note regarding cases: Data not discussed are considered insignificant or irrelevant to the case. Conventional units are given only for biochemical data, since reporting of CBC results in SI units is more universal and conversion to conventional units is easily accomplished by moving decimal points. The cases are all real and data have not been manipulated in any way.

Aphrodite, a 4-year-old F(s) DLH cat, had anorexia, lethargy, and vomiting for 4 days.
The Hct and Hgb are mildly elevated and the RBC count is high normal. Total protein on the biochemical panel is high normal and there is a mild hyperalbuminemia. Total protein (solids), as measured by refractometry on the CBC, is less accurate than the biochemical determination. These findings, together with the history, suggest that the erythrocytosis is relative and due to dehydration.
There is a very mild leukocytosis, which is due to moderately increased band neutrophils and a mild monocytosis. The toxic change indicates accelerated release of neutrophils from the bone marrow. There is a significant inflammatory process, which may warrant follow-up CBC to determine if the bone marrow can continue to meet the demand for neutrophils.
Platelets often clump in feline blood samples; however, numbers are likely to be adequate in this case.
Decreases in sodium and chloride may be due to both decreased intake (anorexia) and increased losses (intestinal). However, chloride is also low relative to sodium, indicating selective chloride loss that can occur with gastric or duodenal foreign body, tumor, or swelling and inflammation leading to obstruction, or with gastrinoma (rare). The hypochloremic metabolic alkalosis also supports upper intestinal pathology. The mild hypocalcemia may not be significant. Mild urea elevation could be due to decreased renal perfusion or intestinal bleeding. Urinalysis would be required to assess renal function. Mild hyperglycemia is likely due to stress in this cat. Very mild hyperbilirubinemia may be secondary to bile stasis from anorexia or sepsis.


The CBC from day 3 is within reference limits. The absolute erythrocytosis and the inflammation were corrected with conservative therapy. Although a foreign body was suspected initially, Aphrodite recovered completely without surgical intervention.

Lady, a 15-year-old F(s) Chihuahua X dog, had lethargy and a severe heart murmur.
The Hct, Hgb, and RBC count are all mildly increased, indicating erythrocytosis. Although the RDW is increased, this does not correlate with an increase in anisocytosis. The total solids are not increased. There is a mild neutrophilia, very mild left shift, lymphopenia, and mild monocytosis. The leukogram changes are consistent with stress (high levels of endogenous cortisol).
The chloride is decreased relative to the sodium, suggesting selective chloride loss, possibly from vomiting (not given in the history). There is a high anion gap metabolic acidosis, which may be due to decreased tissue perfusion. The mild azotemia (increased phosphorus, urea, and creatinine) is likely pre-renal from reduced renal perfusion, given the urine specific gravity (SG). Mild hyperglycemia and hypercholesterolemia are unlikely to be clinically significant. Mildly increased alkaline phosphatase (ALP) activity could be due to cholestasis or enzyme induction from chronic stress/elevated cortisol.

The urine SG indicates adequate renal function. Protein at 2+ could be significant; however, this could be better assessed by urine protein to creatinine ratio. Blood reaction appears to be due to mild hematuria. This is a free flow sample, so hematuria is unlikely to be iatrogenic (as seen with cystocentesis sampling), unless the bladder had been manually compressed to obtain the sample.

• The erythrocytosis is likely to be absolute and secondary to cardiac disease. EPO levels would be expected to be elevated because the erythrocytosis is a physiologic response to decreased arterial pO2 caused by heart failure.
Roxy, a 12.5-year-old F Old English Sheepdog X, had anorexia for 5 days. She had been polydipsic, but was no longer drinking at presentation.
There is a mild to moderate anemia with minimal regeneration. Although the reticulocyte count is 2.2%, the RPI is not increased (>1 indicates regeneration; >3 indicates strong regeneration) and there is no polychromasia noted on RBC morphology. Also, the absolute reticulocyte count is 2.2% × 4.41 × 1012/L = 0.097 × 1012/L, which is only slightly above the reference interval for a normal, nonanemic dog ((0.055–0.085) × 1012/L). There is a moderate to severe leukocytosis characterized by a moderate neutrophilia with a marked left shift, toxic change, and moderate monocytosis. These leukogram changes indicate severe, chronic inflammation.

There is a mild azotemia that must be interpreted in relation to the hydration status of the dog and the urine SG (not available). Moderate elevations in ALP and γ-glutamyltransferase (GGT) activities could be due to cholestasis, enzyme induction, or both. The hypoalbuminemia and low albumin to globulin (A/G) ratio may relate to albumin’s role as a negative acute phase protein.
• The history and laboratory findings support a diagnosis of pyometra in this dog. The anemia is likely due to chronic disease/inflammation. The leukogram abnormalities are due to the demand for phagocytic cells within the uterus. A marked leukocytosis commonly occurs following ovariohysterectomy when pyometra is present. Granulocytic hyperplasia is established in the bone marrow and neutrophils continue to be released into the peripheral blood for several days after the uterus is removed. Since the neutrophils no longer have a focus of inflammation/infection to migrate into, numbers will increase in the circulation (rebound effect). Band cells will eventually decline first, followed by mature neutrophils. The anemia of chronic disease/inflammation will start to correct with resolution of the inflammatory response.


GIZMO, a 8-month old M Poodle dog, was presented in shock with white mucous membranes.
The Hct, Hgb, and RBC count are all severely decreased. Anisocytosis at 2+ and macrocytosis and polychromasia at 1+ could indicate mild/early regeneration, although the reticulocyte count and RPI do not support regeneration. Severe hypoproteinemia and severe anemia suggest acute blood loss. Platelet numbers are decreased, although an absolute platelet count is not available. Severe hemorrhage, internal or external, can result in significant platelet loss. Absolute numbers are not expected to become <80 × 109/L as a result of acute hemorrhage. Leukocyte numbers are within reference limits; however, there is a mild left shift and moderate lymphopenia. Given the state of shock in which the animal was presented, these leukogram changes could be entirely due to stress.
• Gizmo had ingested a rodenticide that contained a vitamin K antagonist. The dog had been bleeding into his chest cavity. Sufficient time had lapsed for low-protein interstitial fluid to move into the intravascular space in an attempt to correct the hypotension. Acute blood loss, whether internal or external, is typically accompanied by hypoproteinemia. Indications of regeneration should start to appear within 2–3 days in the dog.
REX, a 14-year-old M(c) German Wirehair Pointer dog, had lethargy, diarrhea (possibly with melena), and pale mucous membranes.
There is a moderate to severe anemia that is microcytic (low MCV and microcytosis on RBC morphology), hypochromic (low MCH and MCHC, and hypochromia noted on RBC morphology), and regenerative (increased reticulocytes and RPI, and 2+ polychromasia on smear examination). The leukogram changes include a moderate to marked neutrophilia, moderate monocytosis, and mild to moderate eosinophilia. Platelet numbers are increased. The erythrogram findings suggest iron deficiency anemia. The leukogram findings suggest chronic inflammation; eosinophilia may be due to concurrent eosinophilic inflammation, allergic disease, parasitic disease, mast cell neoplasia, or a paraneoplastic mechanism (seen most commonly with lymphoid neoplasms). Thrombocytosis may accompany iron deficiency, although the mechanism is not understood; platelets may also be involved in inflammatory processes.

• Rex had an intestinal leiomyosarcoma that had resulted in mucosal ulceration in the duodenum, chronic blood loss, and iron deficiency. The inflammatory leukogram is probably also related to the focus of ulceration, as no other explanation could be found for these changes. Iron deficiency anemia in older dogs is usually caused by intestinal ulceration from chronic nonsteroidal anti-inflammatory drug administration or by intestinal neoplasia. Careful history taking and ancillary testing, such as imaging studies, should help differentiate the two.